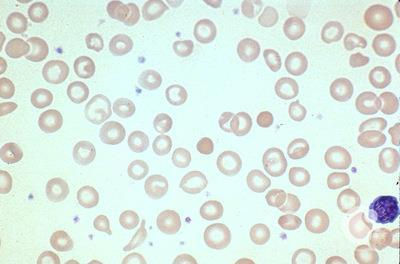
Iron-deficiency anemia

Hemophilia
- mrsaepts
- Feb 26, 2025
- 5 min read
Written by: Pimlapas Smitthapipat, Pisira Leelasa-nguan, Phattarathida Thitathanakit
Edited by: Napat Naiyavitit, Natthara Boosamund
Introduction
Hemophilia is a rare disorder in which patients bleed excessively due to low levels of blood clotting factors. Patients diagnosed with hemophilia bleed for a long period of time after being wounded. Hemophilia is a genetic disorder, in most cases, and in minority, it is acquired during pregnancy or if the patient has an autoimmune disease. The condition is usually not deadly unless the patient has a severe case that involves internal bleeding, which can be life-threatening.
Cause & Symptoms
Symptoms
Hemophilia - caused by mutations in the genes that control of the production of clotting factors / deficiency of clotting factors
- Factor VIII (F8)
- Factor IX (F9)
The symptoms of hemophilia depend on how clotted your blood is. While patients with milder blood clotted levels bleed after surgery or trauma, those with more severity, bleed often without cause. The symptoms include:
Excessive bleeding from injuries
Large or deep bruises
Pain and swelling in joints
Blood in urine or stool
Excessive bleeding during menstruation or delivery in pregnancy
While patients with milder conditions of hemophilia may experience longer period of bleeding after serious injuries, and excessive bleeding during menstruation or delivery in pregnancy.
A rare but serious condition can occur in the brain as well. In rare cases, when a severed condition patient bumps their heads, it can cause internal bleeding within the brain. It could lead to painful headaches, vomiting, and seizures.
Causes
Hemophilia is inherited from parents in most cases; the genes which control the clotting factor (F8 and F9) production are changed, causing deficiency of clotting factor, known as platelets. Males are more likely to inherit hemophilia because either of the mutated genes on the X chromosomes are passed down to males with an XY chromosome.
Females, who are the carriers, are less likely to develop hemophilia due to their XX chromosomes; if one possesses a mutated gene, the other X chromosome can still produce a regular clotting factor. Although, they may be diagnosed with milder symptoms of hemophilia, caused from having low enough levels of clotting factors. There are 3 types of hemophilia, all differs in clotting factors:
Hemophilia A: or the most common type of hemophilia that most patients develop. It is caused by mutations in the F8 gene which controls clotting factor VIII.
Hemophilia B: or known as the “Christmas disease” is caused by mutations in the F9 gene which controls clotting factor IX.
Hemophilia C: Rarer and milder than the rest, because it is caused by mutations in the F11 gene, placed on a different chromosome, which controls the clotting factor XI. Since the gene is on a different chromosome, both genders can inherit this mutated gene and condition.
However, there are rare cases where patients develop hemophilia without family history. In this case, proteins in the immune system damage the clotting factor. This can happen if you are diagnosed with an autoimmune disorder, or during or shortly after pregnancy.
Risk Factors
Hemophilia is a disease that passes through family genetics and can not be cured. The main risk factors for this illness depend on your family's medical history and whether hemophilia is present. In this case the risk of having hemophilia will increase the more your bloodline is close to the member who has hemophilia.
Treatment
While there is no cure for hemophilia, specific treatments are available for each type to help patients manage their symptoms. The standard treatment usually involves replacing the clotting factor the patient is missing through a tube in a vein.
Hemophilia A: Can be treated on-demand with injections of octocog alfa or desmopressin – a synthetic hormone that works by stimulating the production of clotting factor 8. The side effects of desmopressin, however, may include headache, stomach pain, and nausea.
Hemophilia B: Usually treated with factor replacement therapy, in which providers inject concentrated factor 9, which takes the place of the missing factor and prevents excessive bleeding, into the patient's bloodstream. This, however, does not happen regularly unless the patient has severe hemophilia B.
Hemophilia C: Healthcare providers often use a combination of fresh frozen plasma (FFP) and medication for treatment in cases with hemophilia C. However, because FXI is not concentrated in FFP, large amounts of it may be needed, which can lead to blood clots.
For cases of women with long-lasting or heavy menstrual cycles, birth control pills may be prescribed.
Aside from the treatments mentioned, other treatments for hemophilia include:
Hemlibra (ACE 910/ Emicizumab) : Replacing the function of factor 9 instead of replacing the missing clotting factor directly.
DDAVP (Stimate/Desmopressin acetate) : Medications that release factor 9 from its storage in body tissues (increases the patient’s factor levels so that they do not have to use clotting factors to stop bleeding episodes).
Amicar (Epsilon amino caproic acid) : Medication given through a vein or by mouth (as a pill or a liquid) which prevents blood clots from breaking down. Amicar is often used for oral bleeding or after a dental surgery as it blocks a substance found in the saliva that breaks down blood clots.
Roctavian (Valoctocogene roxaparvovec-rvox) : A gene therapy given once as an injection of a virus modified to carry a gene for clotting factor 9 into a vein.
Hemgenix (Etranacogene Dezaparvovec) : A gene therapy for the treatment of hemophilia B, given once as an injection of a virus modified to carry a gene for clotting factor 9 into a vein.
Conclusion
In conclusion, hemophilia or bleeding disorders is a disease which is caused by irregular genetics in X chromosomes affecting clotting factor production to decrease. The decreasing amount of clotting factor needed to block the wound and stop bleeding makes the symptoms of people who get hemophilia take more time for bleeding to stop. This noncommunicable disease was passed through genetics from parents’ offspring and is the only risk factor for this disease. As for treatment, the disease can not be cured directly, but there are specific treatments for each type of hemophilia in order to control the symptoms by giving them medicine or treatment to increase clotting factor in the vein.
Works Cited
“Hemophilia.” Pennmedicine.Org, www.pennmedicine.org/for-patients-and-visitors/patient-information/conditions-treated-a-to-z/hemophilia#. Accessed 21 Aug. 2024.
“Hemophilia - Symptoms and Causes - Mayo Clinic.” Mayo Clinic, 29 Aug. 2023,
.Accessed 19 Aug. 2024.
“Researching a Treatment for Hemophilia.” Wake Forest University School of medicine. https://school.wakehealth.edu/research/institutes-and-centers/wake-forest-institute-for-regenerative-medicine/research/cell-and-gene-therapy-research/researching-a-treatment-for-hemophilia. Accessed 21 Aug. 2024.
NHS. “Treatment for Haemophilia - NHS.” Nhs.uk, 23 Oct. 2017, www.nhs.uk/conditions/haemophilia/treatment/#:~:text=People%20with%20haemophilia%20A%20can. Accessed 21 Aug. 2024.
“Hemophilia B: Definition, Symptoms & Treatment.” Cleveland Clinic, my.clevelandclinic.org/health/diseases/23912-hemophilia-b#management-and-treatment. Accessed 21 Aug. 2024.
“Factor XI | NBDF.” National Bleeding Disorders Foundation, www.bleeding.org/bleeding-disorders-a-z/types/other-factor-deficiencies/factor-xi.
Accessed 21 Aug. 2024.
Cleveland Clinic. “Hemophilia c (Factor XI Deficiency): What It Is, Symptoms & Treatment.” Cleveland Clinic, 20 June 2022,
my.clevelandclinic.org/health/diseases/23337-hemophilia-c. Accessed 21 Aug. 2024.
CDC. “Treatment of Hemophilia.” Hemophilia, 2024, https://www.cdc.gov/hemophilia/treatment/index.html. Accessed 21 Aug. 2024.
“Bleeding Disorders - Causes and Risk Factors | NHLBI, NIH.” www.nhlbi.nih.gov, www.nhlbi.nih.gov/health/bleeding-disorders/causes. Accessed 21 Aug. 2024.

Comments